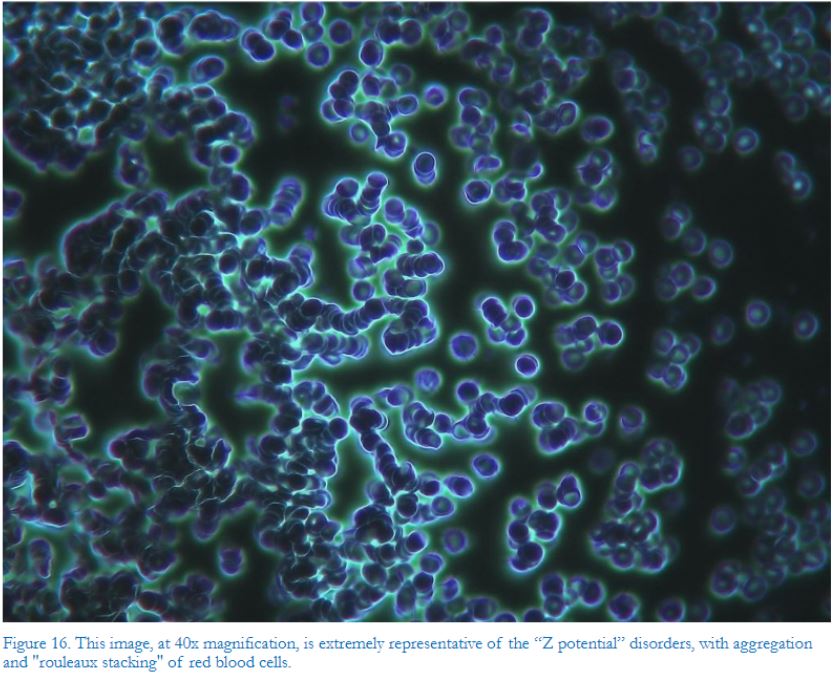

Прим.Ред. - Дорогие братья и сестры! Почему мы столько внимания уделяем теме т.н. вакцинации от т.н. ковида? Потому что это на сегодня одна из самых важных тем. Людей этими жижами калечат и убивают. И не в переносном смысле, а в самом что ни на есть прямом.
НОВОЕ ИССЛЕДОВАНИЕ ПОКАЗАЛО... Привитая кровь — это зараженная кровь! (ФОТО) Еще и еще раз повторяем, что ВСЕ жижи, независимо от страны, одинаковы в своей основе, т.к. разлиты из одной биллгейтовской "бочки". Никакой путинский жид-убийца Гинцбург никакого Спутника-V не изобретал. Он только этикетки наклеивал! Еще и еще раз повторяем, что ВСЕ жижи, независимо от страны, одинаковы в своей основе, т.к. разлиты из одной биллгейтовской "бочки". Никакой путинский жид-убийца Гинцбург никакого Спутника-V не изобретал. Он только этикетки наклеивал! Кому-то достаточно сказать, что в жижах содержатся клетки убитых младенцев - и этого человеку достаточно, чтобы отказаться от осквернения своего тела и души этими жижами. А кому-то нужно такого рода результаты научных исследований с фотографиями и видео. Помоги и вразуми, Господи, наших людей! Господи, помилуй! Новое исследование из Италии предполагает, что у каждого, кто был “полностью вакцинирован” от уханьского коронавируса (Covid-19), теперь зараженная кровь, отмеченная загадочными частицами различных размеров и форм. Итальянское исследование, опубликованное две недели назад в Международном журнале теории, практики и исследований вакцин (“IJVTPR”), показало, что почти у всех, кому была сделана инъекция, были отклонения после “вакцинации против Covid”. В крови 94% вакцинированных наблюдалась агрегация эритроцитов и присутствие частиц различных форм и размеров. Исследование, опубликованное в Международном журнале теории, практики и исследований вакцин (IJVTPR) "В исследовании, опубликованном в Международном журнале теории, практики и исследований вакцин (IJVTPR), которое началось в марте 2021 года, были изучены образцы крови 1006 пациентов, которым сделали укол, у которых впоследствии развились различные расстройства". Авторы исследования отметили, что предполагается, что “вакцины” содержат, по крайней мере, спайковый белок из SARS–CoV-2, но, как известно, также содержат инородные частицы, которых, как утверждали многие промоутеры экспериментальных инъекций, в них вообще не было. “Среди этих инородных компонентов есть металлические предметы, как было продемонстрировано ранее в этом журнале Lee et al. (2022), что подтверждается нашими результатами”. Из проанализированных 1006 случаев только у 58 – что составляет 5,77% от общего числа – при микроскопическом анализе после последней инъекции мРНК смесью Moderna или Pfizer – была полностью нормальная гематологическая картина. Кровь 948 – 94% участников исследования – показала скопление эритроцитов и присутствие частиц различной формы и размера неясного происхождения через месяц после инъекции мРНК. "У 12 субъектов кровь была исследована тем же методом перед вакцинацией, что показало совершенно нормальное гематологическое распределение. Изменения, обнаруженные после прививки инъекций мРНК, еще больше усиливают подозрение, что изменения были вызваны самими так называемыми “вакцинами”. Мы сообщаем о 4 клинических случаях, выбранных в качестве репрезентативных для всей серии случаев. Необходимы дальнейшие исследования, чтобы определить точную природу частиц, обнаруженных в крови, и определить возможные решения проблем, которые они, очевидно, вызывают. Benzi Cipelli, R., Giovannini, F., & Pisano, G. (2022). Микроскопический анализ крови 1006 человек с симптомами после инъекций мРНК против КОВИДА от Pfizer / BioNTech или Moderna в темном поле. Международный журнал теории, практики и исследований вакцин, 2 (2), 385-444." https://doi.org/10.56098/ijvtpr.v2i2.47 Авторы исследования опубликовали фотографии 4 клинических случаев, которые “выявляют странные явления в их крови и иллюстрируют диапазон и типы аномалий, обнаруженных при микроскопическом исследовании крови в 94,23% из 1006 случаев … [эти 4 случая являются] репрезентативными для всех 948 случаев с изменениями периферической крови”. Мы включили некоторые из этих фотографий ниже, сопроводительные описания не требуют пояснений. Рисунок 1. Эти фотографии сделаны с 40-кратным увеличением. На левой стороне (а) показано состояние крови пациента до прививки. На изображении справа (b) показана кровь того же человека через месяц после первой дозы “вакцины” с мРНК Pfizer. Частицы можно увидеть среди эритроцитов, которые сильно конгломерированы вокруг экзогенных частиц; считается, что агломерация отражает снижение дзета-потенциала, отрицательно влияющего на нормальное коллоидное распределение эритроцитов, как показано слева. Эритроциты справа (b) больше не имеют сферической формы и слипаются, как при коагуляции и свертывании.  Рисунок 2. В этом случае сборка частиц приобретает кристаллические черты; кроме того, существует область близкого влияния, крылья бабочки, в контексте которой происходит организация кристаллического типа. Рисунок 3. На изображении при 120-кратном увеличении показаны две экзогенные частицы и скопления фибрина через 2 месяца после вакцинации.  Рисунок 4. На этом изображении при 120-кратном увеличении (3-кратное цифровое увеличение) выделена типичная самоагрегирующаяся структура в волокнисто-трубчатом режиме.  Рисунок 5. Высокоструктурированная волокнисто-трубчатая конфигурация структур, которые могут сливаться вместе, достигая размеров, в десять раз превышающих их первоначальный размер. На (а) и (б) при 40-кратном увеличении мы видим то, что кажется ламинарной связью. В (c) при 120-кратном увеличении (3-кратное цифровое увеличение) показан композит длиной 166,54 мкм (программное обеспечение DeltaPix). Рисунок 6. Более четкое и увеличенное изображение слева, по-видимому, указывает на способность экзогенных частиц, введенных в кровь реципиентов инъекции мРНК, собираться в массивные структуры: мы можем видеть как на (а), так и на (б) при 120-кратном увеличении свидетельства того, что кажется пластинчатыми конфигурациями, похожими на агломерации, происходящие в поле сил, притягивающих коллоидные частицы в плазме друг к другу. Относительный объем конглобата частиц можно легко оценить путем сравнения с эритроцитами на периферии гораздо большей массы. Он также был измерен с точностью 113,91 мкм на 139,99 мкм (см. зеленые линии штриховки на рисунке в) с использованием программного обеспечения Delta-Pix, как показано на снимке экрана компьютера справа. Рисунок 7. (а) Фотография слева с увеличением в 40 раз показывает состояние крови пациента до прививки. (б) Изображение справа, также при 40-кратном увеличении, показывает деформацию профиля эритроцитов и сильную тенденцию к агрегации деформированных эритроцитов. В данном случае речь шла о женщине 54 лет, симптомы которой включали резистентную к лекарствам сильную головную боль, глубокую ухудшающуюся астению, нарушения ритма сна/бодрствования, генерализованные парестезии и дизестезии, психические проявления с депрессивным настроением после второй дозы вакцины Pfizer. Ее анализ крови показан на рисунках с 7 по 9. Рисунок 9. (а) Агрегированные/конглобированные эритроциты с гемолизом и сгустками фибрина при 40-кратном увеличении. (б) Раздутое изображение чужеродной сложной кристаллической структуры при 120-кратном увеличении. Рисунок 8. (а) Деформация и скопление эритроцитов с признаками гемолиза при 40-кратном увеличении. (б) Инородная кристаллизованная трубчатая структура при 120-кратном увеличении.  Рисунок 10. (а) На фотографии вверху и в центре показано состояние крови пациента с 40-кратным увеличением перед первой прививкой мРНК. Изображения в (b) и (c), при 120-кратном увеличении, слева и справа внизу рисунка, показывают объемный агломерат (измеренный при 329,14 мкм на 137,74 мкм с помощью программного обеспечения DeltaPix) через пять недель после вакцинации. Являются ли эти металлические предметы частицами графена? Рисунок 14. На фотографиях (а) и (б), сделанных при 120-кратном увеличении, показаны конфигурации трубчатых, чешуйчатых, кристаллических и смешанных форм, окруженные скоплениями фибрина. (Измерение: 146,72мкм X 31,03мкм -62,00мкм X 61,59мкм Программное обеспечение Delta-Pix). Рисунок 15. Вот несколько очень гладких и сложных кристаллических конфигураций при 120-кратном увеличении. Рисунок 16. Это изображение при 40-кратном увеличении является чрезвычайно репрезентативным для расстройств “Z-потенциала” с агрегацией и «укладкой руло» эритроцитов. Рисунок 17. Пример сложной и структурированной кристаллической/пластинчатой организации при 120-кратном увеличении. На рисунке справа показан «модуль» из морфологии и повторяющегося структурирования, встречающегося с большой частотой. Агрегирующие силы руководствуются негативным энтропийным контекстом. Рисунок 18. Изображения кристаллической агрегации, регулярной и модульной, с очевидными «самоподобными отношениями фрактальной природы». Рисунок 23. Иллюстративные изображения (а) и (б) при 120-кратном увеличении, показывающие различные типы формирующихся скоплений. Рисунок 24. Очевидные трубчатые образования при 120-кратном увеличении в фазе агрегации, демонстрирующие их сложную морфологию. Рисунок 25. Здесь при 120-кратном увеличении (3-кратное цифровое увеличение) (а) и (б) показаны трубчатые образования, которые, по-видимому, находятся на разных стадиях агрегации. Рисунок 26. На этом изображении при 40-кратном увеличении кажется, что эритроциты адсорбируются на структурах частиц. В разделе «Обсуждение и заключение» авторы написали: "Была выделена агрегация эритроцитов и обнаружены экзогенные точечные и самосветящиеся частицы в темном поле. Свечение этих частиц было заметно выше, чем у насыщенных кислородом стенок эритроцитов. В 948 случаях были обнаружены трубчатые / волокнистые образования, а часто также кристаллические и пластинчатые образования с чрезвычайно сложной, но неизменно сходной морфологией у всех пациентов с аномальными образцами крови. образцы крови." Наши результаты настолько похожи на результаты Lee et al. (2022), что можно утверждать, что, за исключением нашего инновационного применения микроскопии в темном поле для маркировки инородных металлоподобных объектов в крови после инъекций мРНК от Pfizer или Moderna, мы повторили анализ крови корейских врачей с гораздо большей выборкой. Что кажется достаточно очевидным, так это то, что металлические частицы, напоминающие оксид графена и, возможно, другие металлические соединения, подобные тем, которые были обнаружены Гатти и Монтанари (Montanari & Gatti, 2016; Gatti & Montanari, 2012, 2017, 2018), были включены в коктейль из того, что производители сочли нужным добавить в so– так называемые мРНК- “вакцины”. "По нашему опыту врачей, эти инъекции мРНК очень не похожи на традиционные “вакцины”, и, по нашему мнению, их производителям необходимо рассказать о том, что содержится в инъекциях и почему они там находятся." В заключение, такие резкие изменения, которые мы зафиксировали в профиле периферической крови 948 пациентов, никогда не наблюдались после прививки какими–либо вакцинами в прошлом, согласно нашему клиническому опыту. Внезапный переход, обычно во время второй инъекции мРНК, из состояния совершенной нормальности в патологическое, с сопутствующим гемолизом, видимой упаковкой и укладкой эритроцитов в сочетании с образованием гигантских конгломератных инородных структур, некоторые из которых выглядят как суперструктуры семейства графена, беспрецедентно. "По нашему коллективному опыту и нашему общему профессиональному мнению, большое количество частиц в крови реципиентов инъекции мРНК несовместимо с нормальным кровотоком, особенно на уровне капилляров. Benzi Cipelli, R., Giovannini, F., & Pisano, G. (2022). Микроскопический анализ крови 1006 человек с симптомами после инъекций мРНК против КОВИДА от Pfizer / BioNTech или Moderna в темном поле. Международный журнал теории, практики и исследований вакцин, 2 (2), 385-444." https://doi.org/10.56098/ijvtpr.v2i2.47 Что это значит Все пациенты получили инъекцию мРНК (мессенджерной РНК) от Pfizer и BioNTech, которые предположительно содержат наименьшее количество фактического белка-шипа от SARS-CoV–2, хотя мы знаем, что эти инъекции мРНК заставляют организм вырабатывать свой собственный белок-спайк. Прививки от covid от Pfizer содержат множество посторонних компонентов, которые итальянские исследователи назвали “металлическими предметами”. Считается, что одним из них является графен, проводящий металл, используемый в радиочастотной электронике. Из проанализированных 1006 случаев только у 58 из них, или у 5,77 процента, при микроскопическом анализе была выявлена нормальная гематология, что означает, что кровь была здоровой. "Было обнаружено, что остальные 94,23 процента образцов были заполнены посторонними предметами “неясного происхождения». “Была выделена агрегация эритроцитов и обнаружены экзогенные точечные и самосветящиеся частицы в темном поле”, — поясняется в документе. “Свечение этих частиц было заметно выше, чем у насыщенных кислородом стенок эритроцитов”. “В 948 случаях были обнаружены трубчатые / волокнистые образования, а также часто кристаллические и пластинчатые образования с чрезвычайно сложной, но неизменно сходной морфологией у всех пациентов с аномальными образцами крови”. У каждого, кому сделали укол, теперь есть инородная, “транзиторная” кровь Работа повторяет работу команды корейских врачей, которые ранее проанализировали гораздо больший образец уколотой крови и сделали аналогичные открытия. Короче говоря, это что угодно, только не традиционные “вакцины”, и, возможно, это вообще не вакцины. “По нашему опыту клиницистов, эти инъекции мРНК очень отличаются от традиционных ‘вакцин’, и, по нашему мнению, их производителям необходимо честно рассказать о том, что содержится в инъекциях и почему оно там”. Интересно, что в исследовании используется слово “переход” для описания состояния крови человека до и после инъекций. До перехода кровь выглядела и имела “совершенно нормальный вид … с сопутствующим гемолизом”, в то время как после перехода наблюдалась “видимая упаковка и укладка эритроцитов в сочетании с образованием гигантских конгломератов инородных структур, некоторые из которых выглядели как суперструктуры семейства графена”. Назвав это изменение “беспрецедентным”, исследователи пришли к выводу, что перелитая кровь, то есть вакцинированная кровь, “несовместима с нормальным кровотоком, особенно на уровне капилляров”. “Кажется, в этих уколах нет ничего хорошего”, — написал комментатор о результатах исследования. “Держись естественно”. “Сначала они нажимали на удары, теперь они ДЕЙСТВИТЕЛЬНО нажимают на ошибки”, — написал другой, скептически относящийся к новой кампании по поеданию крикета. “Каков химический состав сверчка? Может ли поедание насекомых «питать» сгустки?” “COVID-5G все это время – я вам говорил!” — заметил другой о том, как уколотые теперь ходят по частотным передающим “башням”. “Металлические компоненты, вероятно, самособираются в какой-то передатчик и приемник Bluetooth”, — добавил другой, размышляя о характере этого перехода, который проходит полностью vaxxed. Еще больше информации по теме повреждения крови у тех, кто прошел вакцинацию: Источник: Итальянское исследование, опубликованное в Международном журнале теории, практики и исследований вакцин (“IJVTPR”)
|
31 августа 2022
Просмотров: 6 301